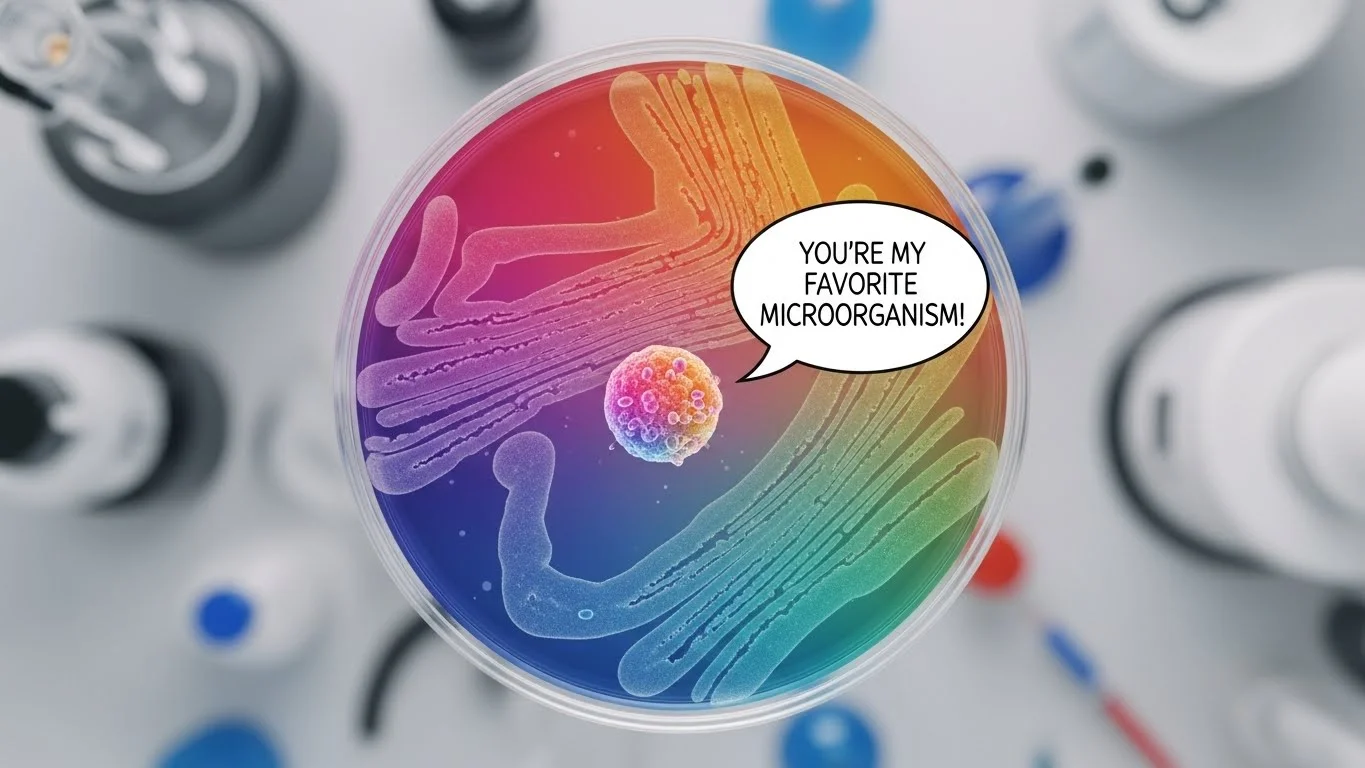
Lab Coat Laughs

If your sense of humor tends to multiply faster than bacteria in a warm Petri dish, you’re in the right lab—because today we’re diving into the wonderfully weird world of bacteria puns. This is where tiny germs deliver huge laughs, blending microbiology humor with clever wordplay that’s geeky, goofy, and genuinely infectious. Get ready for jokes so good, they might just culture a smile on your face.
Table of Contents
ToggleTiny Germs, Big Laughs 😂
Why did the bacteria break up? It needed more space to grow.
My bacteria jokes always spread—sorry, they’re contagious.
The germ opened a bakery; business started to culture.
Bacteria never get lonely—they always divide.
I tried befriending bacteria, but they ghosted me after one cell.
That germ party was wild—everyone multiplied.
Bacteria don’t need WiFi; they have cell-to-cell communication.
My germ buddy is so dramatic—always making a scene.
The bacteria kept bragging… talk about microEGO.
I told a germ joke. It got a viral reaction.
Lab Coat Laughs 🥼
My lab partner told me a germ joke—I said, “You’ve got culture.”
The bacteria asked the microscope out—things got magnified.
Our study group? Total micro-chaos.
The scientist apologized for the mess: “Sorry, things got out of control.”
Germs at the gym? Working on their cell-f improvement.
Bacteria don’t cheat—they follow proper protocols.
The petri dish couple? Total relationship growth.
I tried flirting in the lab—went over like a lead agar plate.
The culture failed… typical group project.
If bacteria could talk, they’d say: “Don’t plaque-shame me.”
Cute-but-Gross Germ Humor 🤏
Bacteria are tiny, but their drama is extra-large.
That germ is adorable—must be a cutie culture.
If bacteria had a dating app, it would be “Cell-Mates.”
Germs don’t ghost—they disinfect.
Bacteria don’t argue—they just split.
Every bacteria wants to be the life of the Petri.
That microbe’s favorite band? Culture Club.
Germs don’t have tea—they spill spores.
Baby bacteria are just little germlins.
Germ gossip spreads faster than viral videos.
Sci-Nerd Humor That Multiplies 🧬
Bacteria puns? I’ve got an endless supply—self-replicating.
Microbes don’t procrastinate—they divide and conquer.
If bacteria ran the world… population would quadruple.
STEM students never quit—they culture resilience.
Bacteria don’t do drama—they evolve.
If evolution had a favorite child, it would be microbes.
Nerds love bacteria jokes—they’re well-contained.
A microbiome walks into a bar… whole place changes.
What’s a germ’s favorite subject? Chem-micro-stry.
Bacteria don’t take selfies—they take cell-fies.
Microbe Jokes for the Whole Family 👨👩👧
Why did the germ go to school? To become well-cultured.
My family laughs at my bacteria jokes—they’re so supportive.
The germ timeouts? In isolation.
Baby germs love storytime—especially “The Very Hungry Microbe.”
Parents tell kids: “Wash up or else you’ll make new microbial friends.”
Family dinner? Bacteria bring extra plates (they multiply).
Germs don’t do chores—they spread them around.
The microbe grandparents? Very cultured.
Bacteria don’t fall asleep—they go dormant.
The family germ reunion was huge—everyone duplicated.
For the Science Classroom and Lab Students 📚
Teachers love bacteria jokes; they always test well.
The class petri dish? Everyone’s emotional support culture.
Students be like: “We studied all night… and the cells still didn’t divide themselves.”
Microbiology homework replicates faster than bacteria.
Lab goggles: The fashion choice of champions.
Students measure success in micrometers.
Bacteria don’t cheat—they follow the scientific method.
Exams feel like survival of the fittest.
Group projects? Pure contamination.
Germs never skip class—they’re everywhere.
Bacteria with Attitude 😎
That germ has swagger—probably antibiotic-resistant.
Microbes walking around like: “We run this body.”
Bacteria don’t care—they’ll colonize anywhere.
Germs don’t argue—they outgrow you.
Bacteria in movies? Always playing the villain.
“Catch me outside”—bacteria literally will.
Germs never pay rent—they’re freeloaders.
Microbes don’t fight—they mutate.
Germs show up uninvited—classic party crashers.
Bacteria don’t flex—they replicate gains.
Relationship Humor, Microbial Edition 💘
Bacteria make great partners—they divide responsibilities.
The relationship had chemistry… and biology.
Bacteria breakups? They just split in half.
“It’s not you, it’s my cellular structure.”
Germs fall in love at first cell.
Couples therapy? Two cultures, one dish.
The germ said, “You complete my cycle.”
Microbes don’t ghost—they lyse.
Relationships thrive when cultures match.
Some couples bond; bacteria conjugate.
Workplace Microbe Humor 💼
Bacteria don’t take breaks—they divide.
Germ office politics? Toxic.
Coworkers spreading gossip—and pathogens.
Bacteria get promotions through rapid growth.
Meetings? Just controlled contamination.
Germs don’t quit—they form spores.
Lunch thieves? Bacteria win every time.
Microbe HR: “Please stop colonizing coworkers.”
Bacteria dress code? Lab chic.
Annual reviews? Based on culture performance.
Germs at a Party 🎉
Bacteria parties are wild—they divide on the dance floor.
Microbes bring the vibe—literally.
Germ DJs always dropping sick beats.
The punch bowl? Contaminated immediately.
Bacteria don’t RSVP—they just show up.
The party theme? Culture shock.
Microbes stay until dawn—no need for sleep.
That one germ always starts something.
The punchline: Everyone got infected.
Germ afterparty? In your immune system.
Foodie Microbes 🍔
Bacteria love leftovers—buffet-style dining.
Fermentation is just fancy bacterial cooking.
“What’s for dinner?” The bacteria choose.
Germs don’t diet—they feast.
Favorite food? Anything room temperature.
Bacteria don’t wash dishes—they grow on them.
Probiotics are just friendly food critics.
Bacteria don’t like hot food—too hostile.
Microbes don’t snack—they colonize.
Germ chefs? Always adding culture.
Traveling Germs ✈️
Bacteria love airports—so many new hosts.
Travel light? Germs pack nothing.
Microbes don’t need passports—they break all boundaries.
Favorite destination? Warm, moist environments.
Germ road trips are short—they’re everywhere already.
Tourist germs love public transport.
Microbes never get jet lag—they adapt fast.
Germ souvenirs? They take pieces of you.
Bacteria don’t do sightseeing—they do site infecting.
Vacation motto: “Spread love… and everything else.”
Bacteria Doing Sports ⚽
Germ olympics: who multiplies fastest.
Bacteria don’t run—they spread.
Microbe yoga: lots of stretching cell walls.
Germs playing soccer? High-contact sport.
Bacteria don’t warm up—they’re always active.
Swimming events happen in your water bottle.
Germ coaches yelling: “Divide! Divide!”
Gym germs love sweaty environments.
Microbe wrestlers are grapplers at a molecular level.
Winning strategy: Outgrow the competition.
Bacteria in Pop Culture 🎬
If bacteria had Netflix, they’d watch “Stranger Strains.”
Favorite superhero? Ant-Man—very relatable.
Germ Oscars: “Best Role in a Host Body.”
Microbes love reality TV—drama is in their DNA.
Famous motto: “May the spores be with you.”
Germ musicians? Always releasing sick tracks.
Bacteria podcasts: “Between Two Cells.”
Microbe influencers are viral by default.
Germ gamers? Total culture grinders.
Celebrity bacteria? Always breaking into the spotlight.
Seasonal Bacteria Humor ❄️🌻🎃
Winter germs love cozying up inside you.
Summer bacteria flourish—heat is their holiday.
Halloween: microbes dress as viruses.
Thanksgiving dinner? Germs bring extra guests.
Springtime: allergy season… and blooming bacteria.
Microbes carol at Christmas—very high pitch.
Autumn germs love pumpkin spice environments.
Holiday travel? They’re already on your luggage.
New Year’s resolution: multiply more.
Valentine’s Day: giving each other culture hearts.
Bacteria in Relationships with Humans 😂
Humans: “Stop bothering me.” Bacteria: “Nah.”
Microbes love close contact—they’re clingy.
Bacteria relationships are one-sided—they take everything.
They’re uninvited roommates for life.
Germs don’t ask permission—they move in.
If bacteria paid rent, we’d all be rich.
They love you… maybe too much.
Microbe love language: colonization.
Their red flags? Literally red inflammation.
Still, some bacteria are probiotics—wholesome roommates.
Germs and Technology 💻
Bacteria don’t need phones—they go viral naturally.
Microbes hate antivirus software—natural enemies.
Tech germs? Always infecting USBs.
Bacteria don’t stream—they spread.
Microbes don’t text—they replicate messages.
Germ AI? Already taking over your keyboard.
Bacteria in servers are hardcore fans of cloud culture.
Microbes have no privacy—they’re everywhere.
Germ gamers love multiplayer modes.
Technology crashes? Blame the bacteria.

Wholesome Probiotic Humor 🌱
Probiotics are the nice germs—Canadian energy.
They’re supportive—literally helping your gut.
Probiotics don’t fight—they negotiate.
They’re the therapy germs everyone needs.
Probiotics write gratitude journals (probably).
If germs could hug, probiotics would.
They’re always like: “Let’s keep things balanced.”
Your gut flora? The nicest neighborhood watch.
Probiotics bring good vibes only.
A true microbe ally.
Spooky Germ Humor 👻
Haunted bacteria: they come back from the dead—spores.
Microbes love dark places—spooky aesthetic.
Bacteria don’t scream—they “EEEEEEE”—like E. coli.
Ghost germs don’t haunt—they infect.
Zombie microbes? That’s just antibiotic resistance.
Horror movie villains wish they were this persistent.
Microbes say “Boo!” and your immune system says “Not today.”
Haunted Petri dish? Classic lab nightmare.
Halloween germs love trick-or-treatment.
Creepy fact: they’re already on your hands.
FAQs
1. Why are bacteria puns so popular online?
Because they mix clever wordplay with science humor, making them perfect for meme culture and viral comedy.
2. Are bacteria puns good for classroom teaching?
Yes! Teachers use them to make microbiology lessons more engaging and memorable.
3. Can bacteria puns be used in science presentations?
Absolutely—adding light humor helps break the ice and boosts STEM communication effectiveness.
4. Are bacteria puns appropriate for all ages?
Most are family-friendly and safe for students, especially when teaching basic microbiology concepts.
5. How do bacteria puns help with learning?
Humor activates memory, helping students retain terms like “cell,” “culture,” and “colony.”
6. What makes a good bacteria pun?
A solid pun usually plays on scientific terms—like “culture,” “cell,” or “viral”—used in a witty, unexpected way.
7. Where can I share bacteria puns for maximum engagement?
They perform well on Reddit, TikTok, and Instagram, especially when paired with science memes.
8. Can I use bacteria puns for social media captions?
Yes—short, punchy puns work great for meme posts, study pages, and biology-themed accounts.
9. Are bacteria puns scientifically accurate?
Many are playful exaggerations, but they still reference real microbial behavior or terminology.
10. Where can I find more humor similar to bacteria puns?
Check out related topics like germ jokes, virus puns, and general science wordplay for more laughs.
Conclusion
If these bacteria puns managed to infect your mood with good vibes, don’t worry—you won’t need antibiotics. The only thing multiplying here is laughter, and honestly, that’s the kind of outbreak we want to spread. So go ahead and share this post with your fellow humor lovers and science nerds. After all, jokes are like bacteria—when they’re good, they replicate fast.

